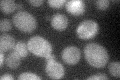
YKR008W
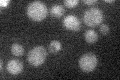
YKR008W

View description
Component of the RSC chromatin remodeling complex; found in close proximity to nucleosomal DNA; displaced from the surface of nucleosomal DNA after chromatin remodeling
Localization:
Intensity:
Fold change:
Significance:
-
C’ GFP library in SD

cytosol21.94 -
N' NOP1pr-GFP in SD

nucleus,nucleolus67.9356 -
N' TEF2pr-mCherry in SD

nucleus67.1886 -
N' NATIVEpr-GFP in SD

nucleus54.6223 -
N' TEF2pr-VC and Cyto-VN in SD

nucleus45.6912 -
C’ GFP library in SD+DTT

cytosol26.991.22No -
C’ GFP library in SD+H2O2
cytosol23.451.06No -
C’ GFP library in Starvation Media
cytosol20.310.92No -
C’ GFP library on the background of Pup2-DaMP

cytosol -
C’ GFP library on the background of CCT mutant

cytosolN/AN/ANo
